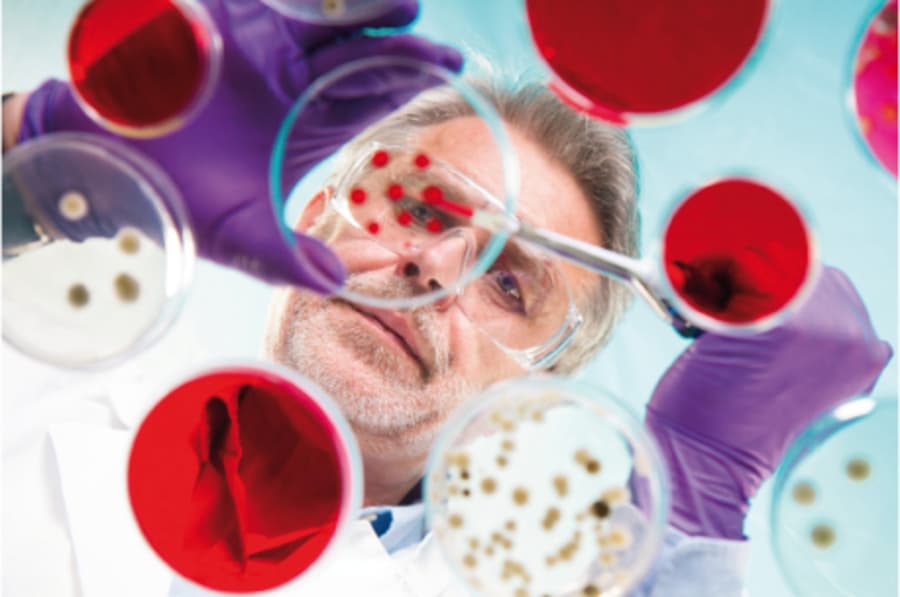

Biologie
Differenzierte Materialien, moderne Methoden und digitale Anwendungen
Lernen, Beobachten oder Experimentieren – mit den fertig ausgearbeiteten Unterrichtseinheiten von RAAbits Biologie lernen Ihre Schüler:innen den eigenen Körper kennen und erwerben Umweltbewusstsein. Dabei steht immer die Praxis im Mittelpunkt! So gestalten Sie Ihren Unterricht abwechslungsreich und zeitsparend. Die Texte und Aufgaben richten sich immer nach dem Alter der Lernenden und sind passend für jede Schulform aufbereitet. Durch moderne Inhalte wie Videos, Apps und Experimente begeistern Sie Ihre Lernenden für das Fach Biologie in allen Klassenstufen und Schulformen.
RAAbits Unterrichtsmaterial Biologie enthält für die Klassen 5-13 am Gymnasium, den Mittleren Schulformen und Beruflichen Schulen
differenzierte Materialien,
moderne Methoden und
digitale Anwendungen
für eine aktuelle Aufbereitung lehrplanrelevanter Themen.
619 Suchergebnisse
Basiswissen im Fach Biologie vermitteln
Besprechen Sie in der 6. und 7. Klasse die Angepasstheit und Evolution der Wirbeltiere. Thematisieren Sie die Wirbeltierklassen mit einem Gruppenpuzzle, einer Mindmap, Bilder und Texten. Die Schüler:innen schauen ein Video über die Zucht von Haus- und Nutztieren und zeichnen einen eigenen Stammbaum. Mit diesen und vielen weiteren Interaktiven Unterrichtseinheiten vermitteln Sie Basiswissen mithilfe von Interaktion und Selbstlernmaterialien. So bilden Sie die Lernenden in den verschiedenen Bereichen der Biologie weiter, während Sie deren Interesse an eigenen Entdeckungen und Erkenntnissen fördern. Dadurch wird bereits in frühen Schuljahren ein wissenschaftlicher Grundgedanke geschaffen und die Klasse zum Mitdenken motiviert.
Zum Grundwissen zählt auch die Humanbiologie mit dem menschlichen Körper und seinen Organen. Sprechen Sie in der 5. und 6. Klasse über das Herz und die Funktion sowie die emotionale Bedeutung des Organs. Die Lernenden beobachten den eigenen Herzschlag in einem Versuch und halten die Pulsschläge in einer Tabelle fest. Sie sprechen über die biologische Struktur des Herzens mit Bildern, Lückentexten und Aufgabenblättern. Darüber hinaus können Sie in den Klassen 5 und 6 zeigen, wie Pflanzen Neuland erobern sowie ein Stationenlernen über die Pflanzenfamilie der Kreuzblütengewächse verwenden. Wenn bisher noch nichts für Sie dabei war, stöbern Sie einfach in unseren Beiträgen und lassen Sie sich inspirieren!
Vielfältiges Material
RAABE bietet Ihnen verschiedenste Formen von Unterrichtsmaterial, damit Sie Ihren Unterricht ganz nach Ihren Vorstellungen gestalten können. Lassen Sie Ihre Lernenden selbstständig durch Texte, Bilder und Tabellen in Einzel- oder Gruppenarbeit die Grundlagen der Evolution erarbeiten. Oder nutzen Sie unsere Unterrichtseinheiten im Bereich Abitur & Prüfungen, um den Lernerfolg Ihrer Klasse abzufragen oder sie auf die nächste große Prüfung, wie das Abitur, vorzubereiten. All diese Einheiten stehen digital für Sie zur Verfügung, sodass sie von überall erreichbar sind. Sie können die Dateien nach eigenen Wünschen anpassen oder passende Ausschnitte direkt mit Ihrer Klasse teilen. RAAbits Unterrichtsmaterial ist darauf ausgelegt, Ihnen die Unterrichtsvorbereitung zu vereinfachen, um dadurch mehr Zeit für individualisierten Unterricht und die Bedürfnisse der Lernenden zu bieten.
Experimente und Projekte im Biologieunterricht
RAAbits Unterrichtsmaterial im Fach Biologie bietet Ihnen viele verschiedene Ansätze, um Experimente in Ihren Unterricht einzubauen. Im Bereich der Botanik können Sie mit Fotosynthese experimentieren, das Mikroskopieren lernen und mithilfe von Apps das Erlernte abfragen. Die Lernenden können die Wirkung verschiedenster Heilkräuter erforschen und in Steckbriefen die Ergebnisse festhalten. Oder stellen Sie mit Ihrer Klasse Bonbons her und vergleichen Sie sie mit gekauften Varianten. Ähnliche Experimente finden Sie auch in unseren anderen Kategorien, wie der Ökologie und Zoologie. So bleibt der Biologieunterricht spannend, abwechslungsreich und motiviert die Schüler:innen zum Mitmachen.